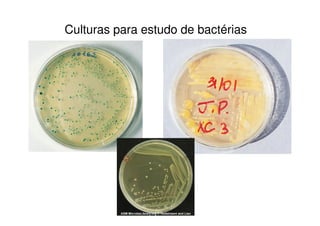
Culturas para estudo de bactérias

O documento discute a estrutura e reprodução de vírus, classificando-os em diferentes grupos e descrevendo seu ciclo de vida. Também aborda a diferença entre vírus e príons, apresentando exemplos de doenças causadas por cada um. Por fim, descreve as estruturas de células procariotas e eucariotas, incluindo revestimentos celulares como a membrana plasmática.